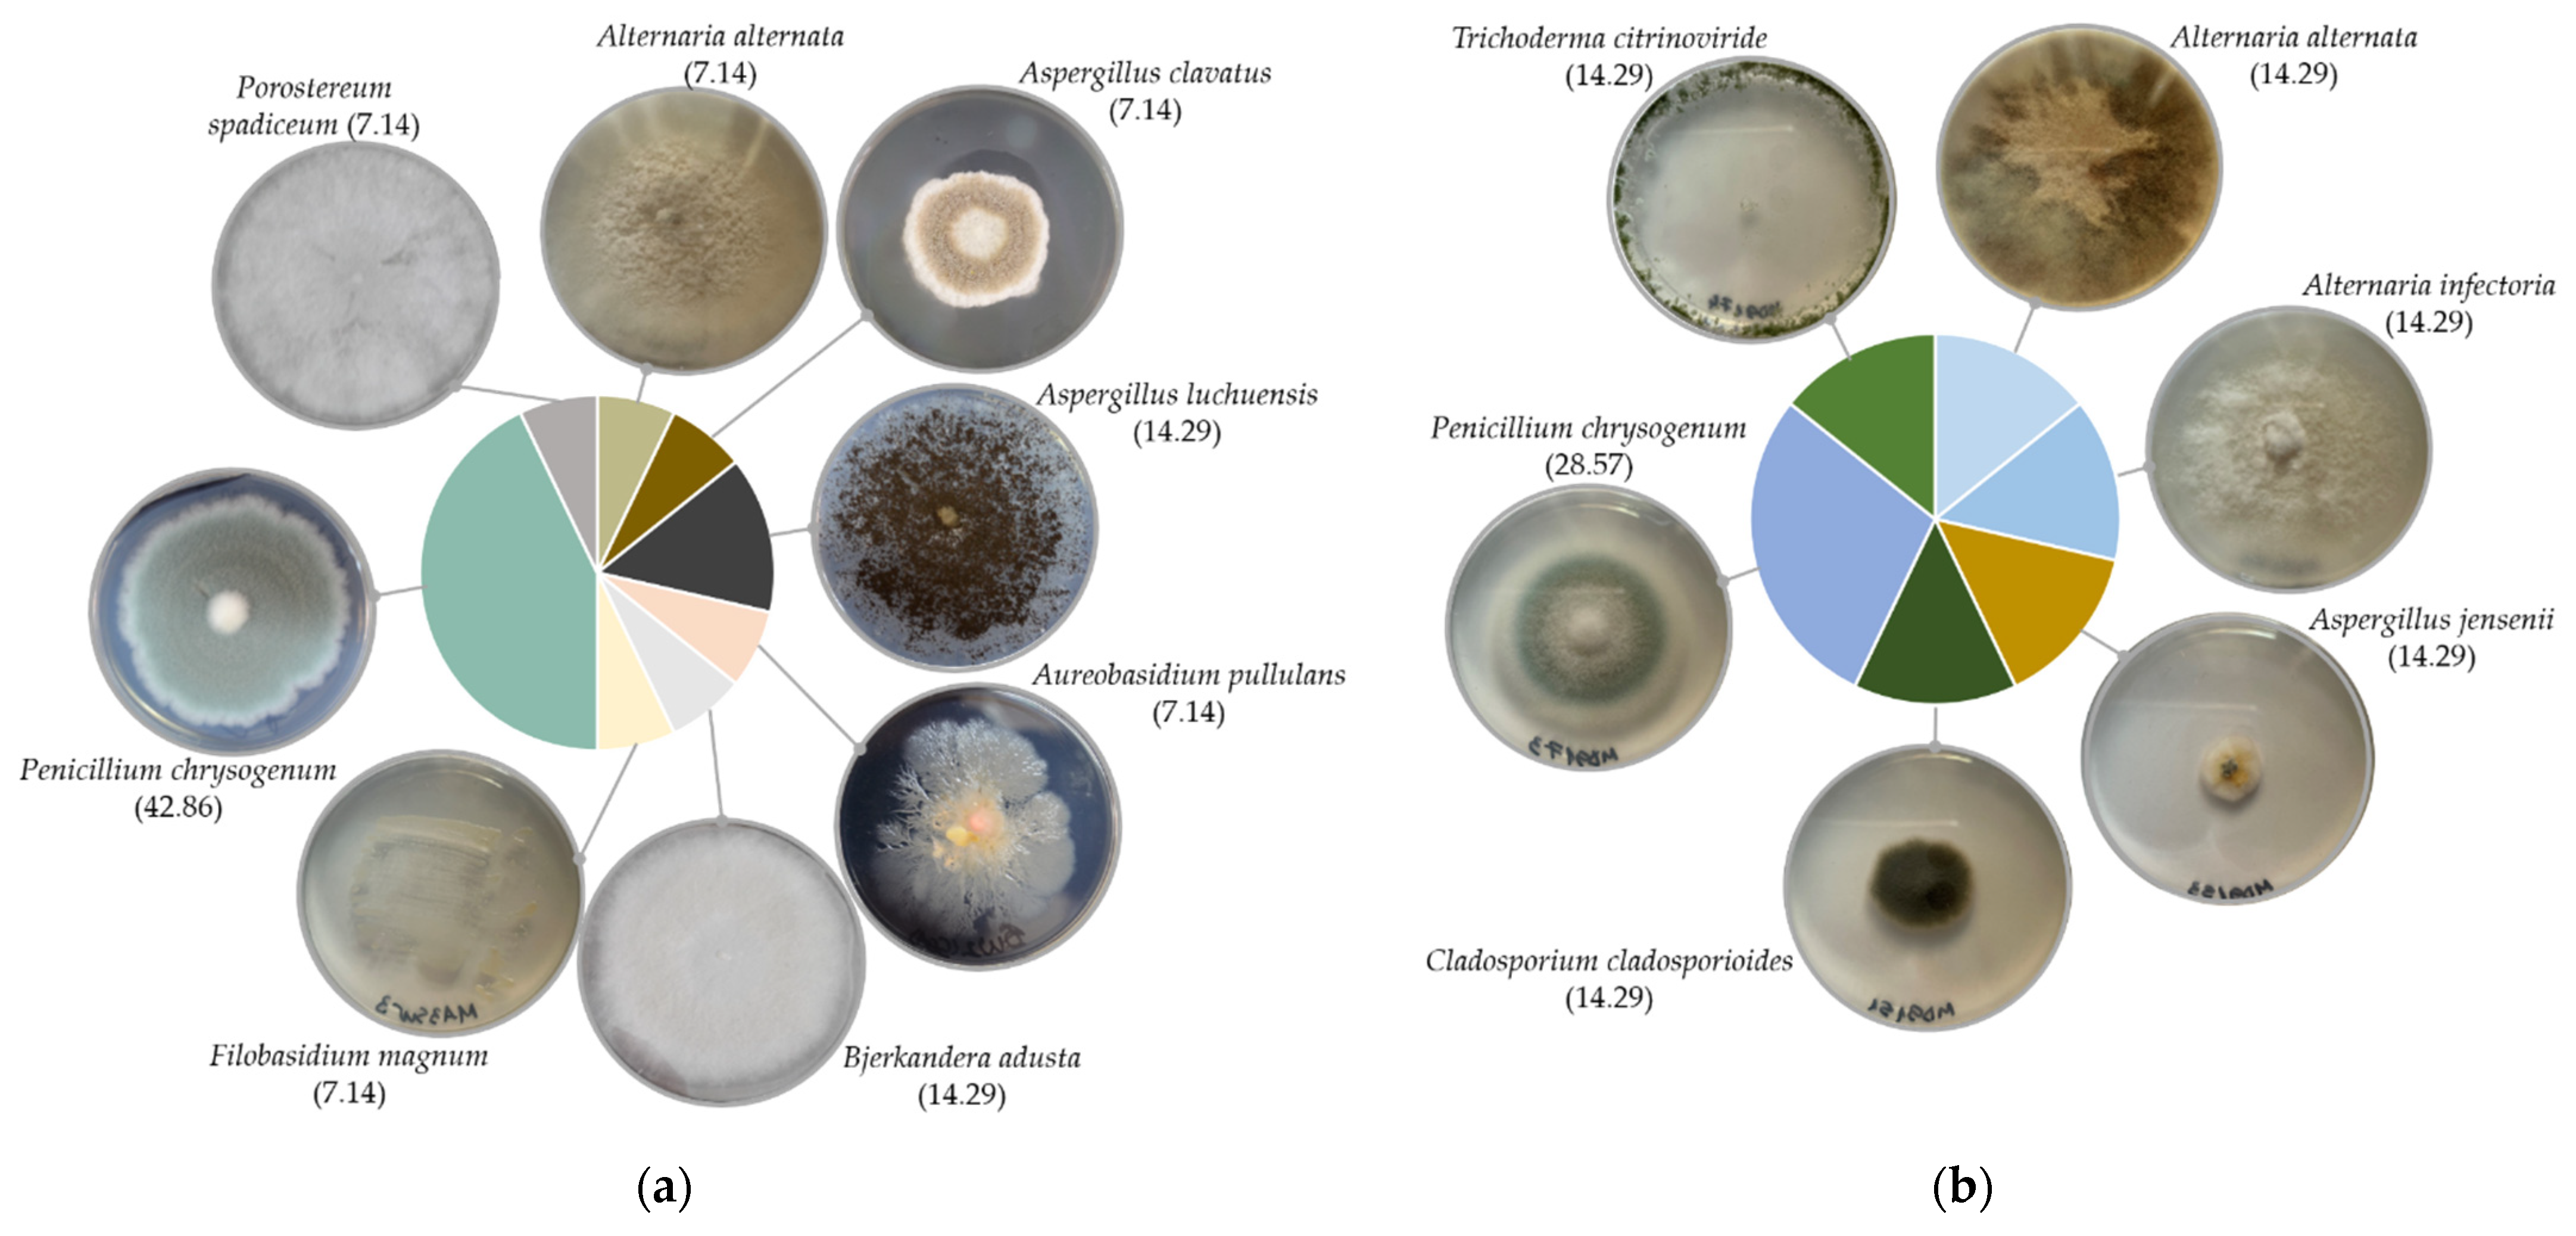
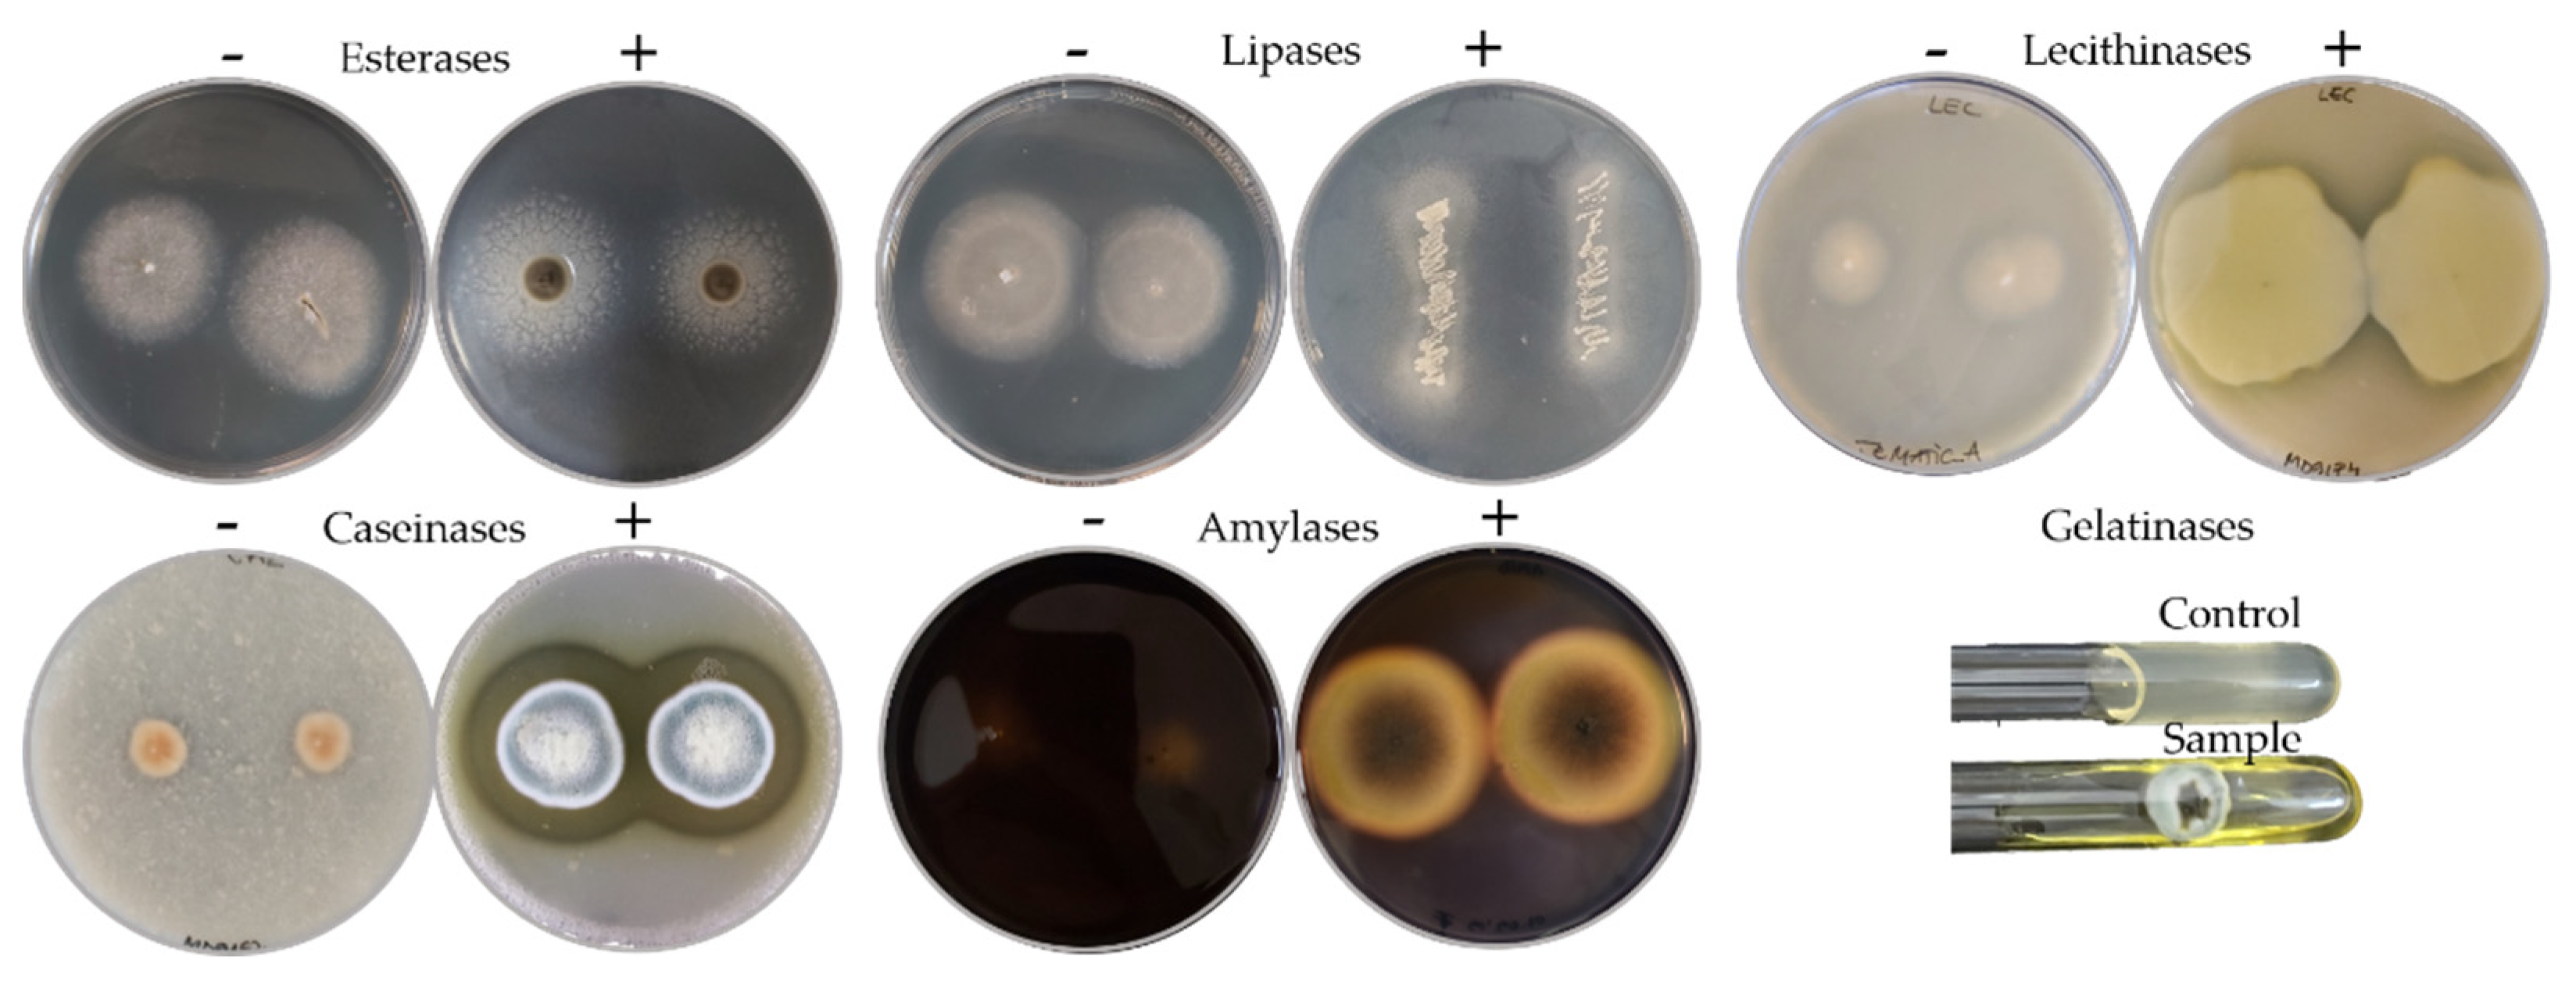
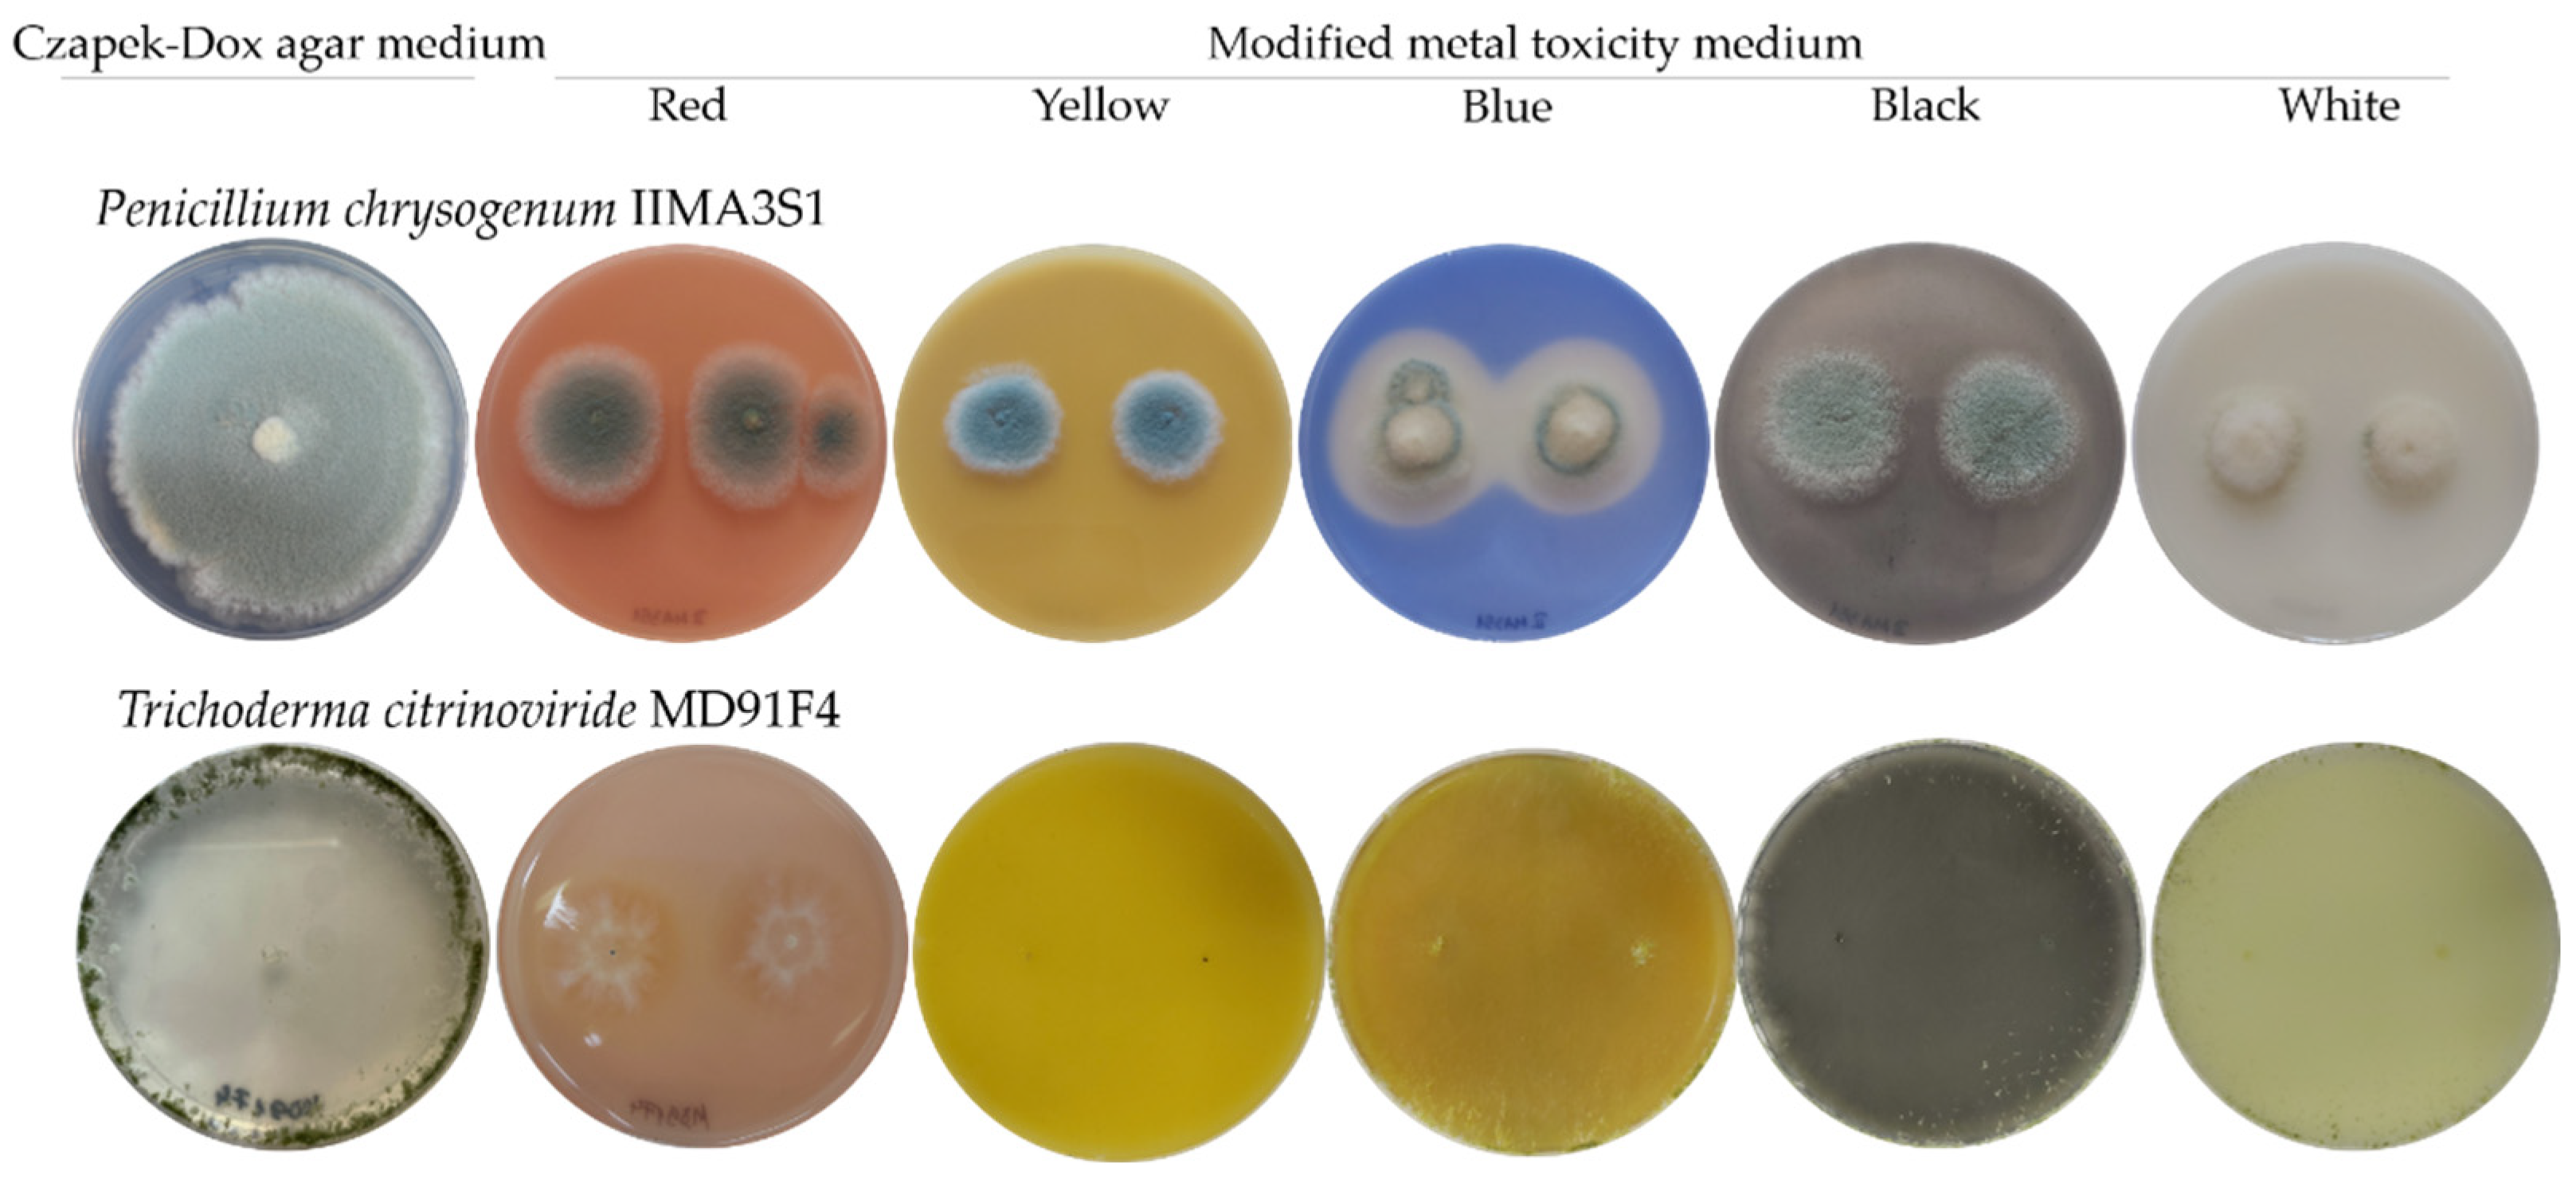

Diversity and Metabolic Activity of Fungi Causing Biodeterioration of Canvas Paintings
Abstract
:1. Introduction
2. Materials and Methods
2.1. Isolation and Identification of Culturable Fungi
2.2. Enzymatic Profile Characterisation
2.3. Pigment Solubilisation Capacity
2.4. Statistical Analyses
3. Results
3.1. Diversity of Culturable Fungi
3.2. Enzymatic Profile Characterisation
3.3. Pigment Solubilisation Capacity
4. Discussion
5. Conclusions
Supplementary Materials
Author Contributions
Funding
Institutional Review Board Statement
Data Availability Statement
Acknowledgments
Conflicts of Interest
References
- Ciferri, O. Microbial degradation of paintings. Appl. Environ. Microbiol. 1999, 65, 879–885. [Google Scholar] [CrossRef] [PubMed] [Green Version]
- Berovic, M. Biodeterioration studies on pastels and oil-based paintings. In Art, Biology, and Conservation: Biodeterioration of Works of Art; Metropolitan Museum of Art: New York, NY, USA, 2003; pp. 50–59. [Google Scholar]
- Sterflinger, K. Fungi: Their role in deterioration of cultural heritage. Fungal Biol. Rev. 2010, 24, 47–55. [Google Scholar] [CrossRef]
- Poyatos, F.; Morales, F.; Nicholson, A.W.; Giordano, A. Physiology of biodeterioration on canvas paintings. J. Cell. Physiol. 2018, 233, 2741–2751. [Google Scholar] [CrossRef] [PubMed]
- Digney-Peer, S.; Thomas, K.; Perry, R.; Townsend, J.; Gritt, S. The imitative retouching of easel paintings. In Conservation of Easel Paintings, 2nd ed.; Stoner Joyce Hill, R.R., Ed.; Routledge: London, UK, 2020; pp. 626–653. [Google Scholar]
- Santos, A.; Cerrada, A.; García, S.; San Andrés, M.; Abrusci, C.; Marquina, D. Application of molecular techniques to the elucidation of the microbial community structure of antique paintings. Microb. Ecol. 2009, 58, 692–702. [Google Scholar] [CrossRef]
- Tiano, P. Biodegradation of cultural heritage: Decay mechanisms and control methods. In Proceedings of the 9th ARIADNE Workshop “Historic Material and their Diagnostic”, ARCCHIP, Prague, Czech Republic, 22–28 April 2002; pp. 7–12. [Google Scholar]
- Soffritti, I.; D’Accolti, M.; Lanzoni, L.; Volta, A.; Bisi, M.; Mazzacane, S.; Caselli, E. The potential use of microorganisms as restorative agents: An update. Sustainability 2019, 11, 3853. [Google Scholar] [CrossRef] [Green Version]
- Nittérus, M. Fungi in archives and libraries. Restaurator 2000, 21, 25–40. [Google Scholar] [CrossRef]
- Sterflinger, K.; Piñar, G. Microbial deterioration of cultural heritage and works of art—tilting at windmills? Appl. Microbiol. Biotechnol. 2013, 97, 9637–9646. [Google Scholar] [CrossRef] [Green Version]
- Zhang, G.; Gong, C.; Gu, J.; Katayama, Y.; Someya, T.; Gu, J.-D. Biochemical reactions and mechanisms involved in the biodeterioration of stone world cultural heritage under the tropical climate conditions. Int. Biodeterior. Biodegrad. 2019, 143, 104723. [Google Scholar] [CrossRef]
- Unković, N.; Grbić, M.L.; Stupar, M.; Savković, Ž.; Jelikić, A.; Stanojević, D.; Vukojević, J. Fungal-Induced Deterioration of Mural Paintings: In Situ and Mock-Model Microscopy Analyses. Microsc. Microanal. 2016, 22, 410–421. [Google Scholar] [CrossRef] [Green Version]
- Ma, Y.; Zhang, H.; Du, Y.; Tian, T.; Xiang, T.; Liu, X.; Wu, F.; An, L.; Wang, W.; Gu, J.-D.; et al. The community distribution of bacteria and fungi on ancient wall paintings of the Mogao Grottoes. Sci. Rep. 2015, 5, 7752. [Google Scholar] [CrossRef]
- Ljaljević-Grbić, M.; Stupar, M.; Vukojević, J.; Maričić, I.; Bungur, N. Molds in museum environments: Biodeterioration of art photographs and wooden sculptures. Arch. Biol. Sci. 2013, 65, 955–962. [Google Scholar] [CrossRef]
- Mazzoli, R.; Giuffrida, M.G.; Pessione, E. Back to the past: “find the guilty bug—microorganisms involved in the biodeterioration of archeological and historical artifacts”. Appl. Microbiol. Biotechnol. 2018, 102, 6393–6407. [Google Scholar] [CrossRef]
- Caselli, E.; Pancaldi, S.; Baldisserotto, C.; Petrucci, F.; Impallaria, A.; Volpe, L.; D’Accolti, M.; Soffritti, I.; Coccagna, M.; Sassu, G.; et al. Characterization of biodegradation in a 17th century easel painting and potential for a biological approach. PLoS ONE 2018, 13, e0207630. [Google Scholar] [CrossRef] [PubMed]
- López-Miras, M.; Piñar, G.; Romero-Noguera, J.; Bolivar-Galiano, F.; Ettenauer, J.; Sterflinger, K.; Martin-Sanchez, I. Microbial communities adhering to the obverse and reverse sides of an oil painting on canvas: Identification and evaluation of their biodegradative potential. Aerobiologia 2013, 29, 301–314. [Google Scholar] [CrossRef] [PubMed] [Green Version]
- López-Miras, M.d.M.; Martín-Sánchez, I.; Yebra-Rodríguez, Á.; Romero-Noguera, J.; Bolívar-Galiano, F.; Ettenauer, J.; Sterflinger, K.; Piñar, G. Contribution of the microbial communities detected on an oil painting on canvas to its biodeterioration. PLoS ONE 2013, 8, e80198. [Google Scholar] [CrossRef] [PubMed] [Green Version]
- Capodicasa, S.; Fedi, S.; Porcelli, A.M.; Zannoni, D. The microbial community dwelling on a biodeteriorated 16th century painting. Int. Biodeterior. Biodegrad. 2010, 64, 727–733. [Google Scholar] [CrossRef]
- Salvador, C.; Sandu, I.C.A.; Sandbakken, E.; Candeias, A.; Caldeira, A.T. Biodeterioration in art: A case study of Munch’s paintings. Eur. Phys. J. Plus 2021, 137, 11. [Google Scholar] [CrossRef]
- Zhgun, A.; Avdanina, D.; Shumikhin, K.; Simonenko, N.; Lyubavskaya, E.; Volkov, I.; Ivanov, V. Detection of potential biodeterioration risks for tempera painting in 16th century exhibits from State Tretyakov Gallery. PLoS ONE 2020, 15, e0230591. [Google Scholar] [CrossRef]
- Pavić, A.; Ilić-Tomić, T.; Pačevski, A.; Nedeljković, T.; Vasiljević, B.; Morić, I. Diversity and biodeteriorative potential of bacterial isolates from deteriorated modern combined-technique canvas painting. Int. Biodeterior. Biodegrad. 2015, 97, 40–50. [Google Scholar] [CrossRef]
- Paiva de Carvalho, H.; Sequeira, S.O.; Pinho, D.; Trovão, J.; da Costa, R.M.F.; Egas, C.; Macedo, M.F.; Portugal, A. Combining an innovative non-invasive sampling method and high-throughput sequencing to characterize fungal communities on a canvas painting. Int. Biodeterior. Biodegrad. 2019, 145, 104816. [Google Scholar] [CrossRef]
- Gardes, M.; Bruns, T.D. ITS primers with enhanced specificity for basidiomycetes—Application to the identification of mycorrhizae and rusts. Mol. Ecol. 1993, 2, 113–118. [Google Scholar] [CrossRef] [PubMed]
- White, T.J.; Bruns, T.; Lee, S.; Taylor, J. Amplification and direct sequencing of fungal ribosomal RNA genes for phylogenetics. In PCR Protocols: A Guide to Methods and Applications; Academic Press: Cambridge, MA, USA, 1990; Volume 18, pp. 315–322. [Google Scholar]
- Rehner, S.A.; Buckley, E. A Beauveria phylogeny inferred from nuclear ITS and EF1-α sequences: Evidence for cryptic diversification and links to Cordyceps teleomorphs. Mycologia 2005, 97, 84–98. [Google Scholar] [CrossRef] [PubMed]
- Glass, N.L.; Donaldson, G.C. Development of primer sets designed for use with the PCR to amplify conserved genes from filamentous ascomycetes. Appl. Environ. Microbiol. 1995, 61, 1323–1330. [Google Scholar] [CrossRef] [PubMed] [Green Version]
- Kumar, D.; Kumar, L.; Nagar, S.; Raina, C.; Parshad, R.; Gupta, V.K. Screening, isolation and production of lipase/esterase producing Bacillus sp. strain DVL2 and its potential evaluation in esterification and resolution reactions. Arch. Appl. Sci. Res. 2012, 4, 1763–1770. [Google Scholar]
- Lányi, B. 1 Classical and rapid identification methods for medically important bacteria. In Methods in Microbiology; Academic Press: New York, NY, USA, 1988; Volume 19, pp. 1–67. [Google Scholar]
- Lee, S.M.; Lee, H.-J.; Kim, S.H.; Suh, M.J.; Cho, J.Y.; Ham, S.; Jeon, J.-M.; Yoon, J.-J.; Bhatia, S.K.; Gurav, R.; et al. Screening of the strictly xylose-utilizing Bacillus sp. SM01 for polyhydroxybutyrate and its co-culture with Cupriavidus necator NCIMB 11599 for enhanced production of PHB. Int. J. Biol. Macromol. 2021, 181, 410–417. [Google Scholar] [CrossRef]
- Tille, P. Bailey and Scott’s Diagnostic Microbiology-E-Book; Elsevier Health Sciences: New York, NY, USA, 2013. [Google Scholar]
- Lal, A.; Cheeptham, N. Starch Agar Protocol; American Society for Microbiology: Washington, DC, USA, 2012; pp. 1–9. [Google Scholar]
- MacWilliams, M.P. Citrate Test Protocol; American Society for Microbiology: Washington, DC, USA, 2009. [Google Scholar]
- Minitab Inc. Minitab Statistical Software; Minitab Inc.: State College, PA, USA, 2014. [Google Scholar]
- Hammer, Ø.; Harper, D.A.; Ryan, P.D. PAST: Paleontological statistics software package for education and data analysis. Palaeontol. Electron. 2001, 4, 9. [Google Scholar]
- Wessa, P. Hierarchical Clustering (v1.0.5) in Free Statistics Software (v1.2.1). Available online: https://www.wessa.net/rwasp_hierarchicalclustering.wasp/ (accessed on 20 April 2022).
- Gatti, L.; Troiano, F.; Vacchini, V.; Cappitelli, F.; Balloi, A. An In Vitro Evaluation of the Biocidal Effect of Oregano and Cloves’ Volatile Compounds against Microorganisms Colonizing an Oil Painting—A Pioneer Study. Appl. Sci. 2021, 11, 78. [Google Scholar] [CrossRef]
- Ortiz-Miranda, A.S.; Doménech-Carbó, A.; Doménech-Carbó, M.T.; Osete-Cortina, L.; Valle-Algarra, F.M.; Bolívar-Galiano, F.; Martín-Sánchez, I.; del Mar López-Miras, M. Electrochemical characterization of biodeterioration of paint films containing cadmium yellow pigment. J. Solid State Electrochem. 2016, 20, 3287–3302. [Google Scholar] [CrossRef]
- Ortiz-Miranda, A.S.; Doménech-Carbó, A.; Doménech-Carbó, M.T.; Osete-Cortina, L.; Bolívar-Galiano, F.; Martín-Sánchez, I. Analyzing chemical changes in verdigris pictorial specimens upon bacteria and fungi biodeterioration using voltammetry of microparticles. Herit. Sci. 2017, 5, 8. [Google Scholar] [CrossRef] [Green Version]
- Ishfaq, S.; Ali, N.; Tauseef, I.; Khattak, M.N.K.; Shinwari, Z.; Ali, M. Analysis of paint degradation by fungal and bacterial species. Pak. J. Bot. 2015, 47, 753–760. [Google Scholar]
- Wang, X.; Schlatter, D.C.; Glawe, D.A.; Edwards, C.G.; Weller, D.M.; Paulitz, T.C.; Abatzoglou, J.T.; Okubara, P.A. Native yeast and non-yeast fungal communities of Cabernet Sauvignon berries from two Washington State vineyards, and persistence in spontaneous fermentation. Int. J. Food Microbiol. 2021, 350, 109225. [Google Scholar] [CrossRef] [PubMed]
- Zhu, S.; Lei, Y.; Wang, C.; Wei, Y.; Wang, C.; Sun, Y. Patterns of yeast diversity distribution and its drivers in rhizosphere soil of Hami melon orchards in different regions of Xinjiang. BMC Microbiol. 2021, 21, 170. [Google Scholar] [CrossRef] [PubMed]
- Aboutalebian, S.; Mahmoudi, S.; Okhovat, A.; Khodavaisy, S.; Mirhendi, H. Otomycosis Due to the Rare Fungi Talaromyces purpurogenus, Naganishia albida and Filobasidium magnum. Mycopathologia 2020, 185, 569–575. [Google Scholar] [CrossRef] [PubMed]
- Hashimoto, K.; Yamazaki, F.; Kohyama, N.; Kawakami, Y. Analysis of Fungal Flora in the Dust of Bedding in Japanese Houses and Genetic Identification of Yeasts Isolated from the Dust. Biocontrol Sci. 2020, 25, 193–202. [Google Scholar] [CrossRef]
- Adams, R.I.; Lymperopoulou, D.S.; Misztal, P.K.; De Cassia Pessotti, R.; Behie, S.W.; Tian, Y.; Goldstein, A.H.; Lindow, S.E.; Nazaroff, W.W.; Taylor, J.W.; et al. Microbes and associated soluble and volatile chemicals on periodically wet household surfaces. Microbiome 2017, 5, 128. [Google Scholar] [CrossRef] [Green Version]
- Glushakova, A.M.; Kachalkin, A.V. Endophytic yeasts in Malus domestica and Pyrus communis fruits under anthropogenic impact. Microbiology 2017, 86, 128–135. [Google Scholar] [CrossRef]
- Andriani, A.; Yanto, D.H.Y. Comparative kinetic study on biodecolorization of synthetic dyes by Bjerkandera adusta SM46 in alginate beads-packed bioreactor system and shaking culture under saline-alkaline stress. Biocatal. Biotransform. 2021, 1–12. [Google Scholar] [CrossRef]
- Gomi, N.; Yoshida, S.; Matsumoto, K.; Okudomi, M.; Konno, H.; Hisabori, T.; Sugano, Y. Degradation of the synthetic dye amaranth by the fungus Bjerkandera adusta Dec 1: Inference of the degradation pathway from an analysis of decolorized products. Biodegradation 2011, 22, 1239–1245. [Google Scholar] [CrossRef]
- Robinson, T.; Nigam, P.S. Remediation of Textile Dye Waste Water Using a White-Rot Fungus Bjerkandera adusta Through Solid-state Fermentation (SSF). Appl. Biochem. Biotechnol. 2008, 151, 618. [Google Scholar] [CrossRef]
- Eichlerová, I.; Homolka, L.; Nerud, F. Decolorization of high concentrations of synthetic dyes by the white rot fungus Bjerkandera adusta strain CCBAS 232. Dye. Pigment. 2007, 75, 38–44. [Google Scholar] [CrossRef]
- Spina, F.; Tigini, V.; Romagnolo, A.; Varese, G.C. Bioremediation of Landfill Leachate with Fungi: Autochthonous vs. Allochthonous Strains. Life 2018, 8, 27. [Google Scholar] [CrossRef] [PubMed] [Green Version]
- Tigini, V.; Spina, F.; Romagnolo, A.; Prigione, V.P.; Varese, G. Effective biological treatment of landfill leachates by means of selected white rot fungi. Chem. Eng. Trans. 2013, 32, 265–270. [Google Scholar] [CrossRef]
- Anastasi, A.; Spina, F.; Romagnolo, A.; Tigini, V.; Prigione, V.; Varese, G.C. Integrated fungal biomass and activated sludge treatment for textile wastewaters bioremediation. Bioresour. Technol. 2012, 123, 106–111. [Google Scholar] [CrossRef] [PubMed]
- Schmidt, O.; Huckfeldt, T. Characteristics and identification of indoor wood-decaying basidiomycetes. In Fundamentals of Mold Growth in Indoor Environments and Strategies for Healthy Living; Wageningen Academic Publishers: Wageningen, The Netherlands, 2011; pp. 117–180. [Google Scholar]
- Pinheiro, A.C.; Sequeira, S.O.; Macedo, M.F. Fungi in archives, libraries, and museums: A review on paper conservation and human health. Crit. Rev. Microbiol. 2019, 45, 686–700. [Google Scholar] [CrossRef]
- Levetin, E.; Horner, W.E.; Scott, J.A.; Chew, G.L.; Miller, D.J.; Portnoy, J.M.; Brock, W.P. Taxonomy of Allergenic Fungi. J. Allergy Clin. Immunol. Pract. 2016, 4, 375–385.e1. [Google Scholar] [CrossRef]
- Singh, P.K.; Kathuria, S.; Agarwal, K.; Gaur, S.N.; Meis, J.F.; Chowdhary, A. Clinical Significance and Molecular Characterization of Nonsporulating Molds Isolated from the Respiratory Tracts of Bronchopulmonary Mycosis Patients with Special Reference to Basidiomycetes. J. Clin. Microbiol. 2013, 51, 3331–3337. [Google Scholar] [CrossRef] [Green Version]
- Ogawa, H.; Fujimura, M.; Takeuchi, Y.; Makimura, K. Is Bjerkandera adusta Important to Fungus-associated Chronic Cough as an Allergen? Eight Cases’ Reports. J. Asthma 2009, 46, 849–855. [Google Scholar] [CrossRef]
- Savković, Ž.; Stupar, M.; Unković, N.; Ivanović, Ž.; Blagojević, J.; Vukojević, J.; Ljaljević Grbić, M. In vitro biodegradation potential of airborne Aspergilli and Penicillia. Sci. Nat. 2019, 106, 8. [Google Scholar] [CrossRef]
- Kumar, S.; Kumar, U. Microbial Community Present on the Reverse Side of a Deteriorated Canvas. In Microbial Biotechnology Approaches to Monuments of Cultural Heritage; Springer: Singapore, 2020; pp. 1–12. [Google Scholar]
- Caneva, G.; Maggi, O.; Nugari, M.; Pietrini, A.; Piervittori, R.; Ricci, S.; Roccardi, A. The biological aerosol as a factor of biodeterioration. In Cultural Heritage and Aerobiology; Springer Science + Business: Dordrecht, The Netherlands, 2003; pp. 3–29. [Google Scholar]
- Cato, E.; Borca, C.; Huthwelker, T.; Ferreira, E.S.B. Aluminium X-ray absorption near-edge spectroscopy analysis of discoloured ultramarine blue in 20th century oil paintings. Microchem. J. 2016, 126, 18–24. [Google Scholar] [CrossRef]
- Derntl, C.; Rassinger, A.; Srebotnik, E.; Mach, R.L.; Mach-Aigner, A.R.; Brakhage, A.A. Identification of the Main Regulator Responsible for Synthesis of the Typical Yellow Pigment Produced by Trichoderma reesei. Appl. Environ. Microbiol. 2016, 82, 6247–6257. [Google Scholar] [CrossRef] [Green Version]
- Druzhinina, I.S.; Kubicek, E.M.; Kubicek, C.P. Several steps of lateral gene transfer followed by events of ‘birth-and-death’ evolution shaped a fungal sorbicillinoid biosynthetic gene cluster. BMC Evol. Biol. 2016, 16, 269. [Google Scholar] [CrossRef] [PubMed] [Green Version]

Publisher’s Note: MDPI stays neutral with regard to jurisdictional claims in published maps and institutional affiliations. |
© 2022 by the authors. Licensee MDPI, Basel, Switzerland. This article is an open access article distributed under the terms and conditions of the Creative Commons Attribution (CC BY) license (https://creativecommons.org/licenses/by/4.0/).
Share and Cite
Văcar, C.L.; Mircea, C.; Pârvu, M.; Podar, D. Diversity and Metabolic Activity of Fungi Causing Biodeterioration of Canvas Paintings. J. Fungi 2022, 8, 589. https://doi.org/10.3390/jof8060589
Văcar CL, Mircea C, Pârvu M, Podar D. Diversity and Metabolic Activity of Fungi Causing Biodeterioration of Canvas Paintings. Journal of Fungi. 2022; 8(6):589. https://doi.org/10.3390/jof8060589
Chicago/Turabian StyleVăcar, Cristina Lorena, Cristina Mircea, Marcel Pârvu, and Dorina Podar. 2022. "Diversity and Metabolic Activity of Fungi Causing Biodeterioration of Canvas Paintings" Journal of Fungi 8, no. 6: 589. https://doi.org/10.3390/jof8060589
APA StyleVăcar, C. L., Mircea, C., Pârvu, M., & Podar, D. (2022). Diversity and Metabolic Activity of Fungi Causing Biodeterioration of Canvas Paintings. Journal of Fungi, 8(6), 589. https://doi.org/10.3390/jof8060589

